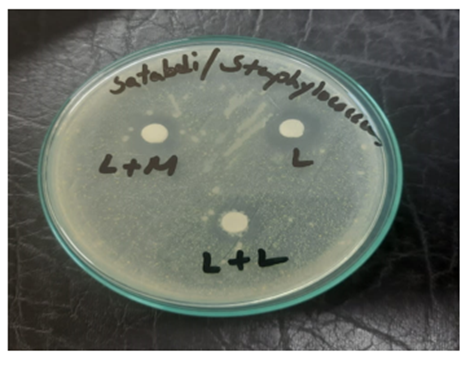

Research Article | DOI: https://doi.org/10.31579/2835-785X/099
In-vitro Interaction Study of Levofloxacin with Metformin HCl and Losartan Potassium and Investigation of Antimicrobial Activity
1 Department of Pharmacy, University of Science and Technology Chittagong (USTC).
2 Associate Professor and Dean, Faculty of Sciences, University of Science and Technology Chittagong (USTC).
*Corresponding Author: © 2025, Md. Shahidul Islam. This is an open-access artic le distributed under the terms of the Creative Commons Attribution License, which permits unrestricted use, distribution, and reproduction in any medium, provided the original author and source are
Citation: Satabdi Nag, Fahmina BintyAzim Nova, Md. Shahidul Islam, (2025), In-vitro Interaction Study of Levofloxacin with Metformin HCl and Losartan Potassium and Investigation of Antimicrobial Activity, International Journal of Clinical Research and Reports. 4(5); DOI:10.31579/2835-785X/099
Copyright: © 2025, Md. Shahidul Islam. This is an open-access artic le distributed under the terms of the Creative Commons Attribution License, which permits unrestricted use, distribution, and reproduction in any medium, provided the original author and source are credited.
Received: 11 August 2025 | Accepted: 22 September 2025 | Published: 01 October 2025
Keywords: interaction; Levofloxacin; Metformin HCl; losartan potassium; job’s plot, zone of inhibition
Abstract
Background: This research work is a drug-drug interaction study between two widely used medications Levofloxacin and Metformin HCl as well as Losartan Potassium and this study is carried out at that time when they are used concomitantly (In- Vitro). Levofloxacin, this medication belongs to class of drugs known as quinolone antibiotics and is used to treat a wide range of gram positive (+) and gram-negative (-) bacterial infections. Metformin HCl is a medicine used to type 2 diabetes and gestational diabetes. Metformin is used with a proper diet and exercise program and possibly with other medications to control high blood sugar. Controlling high blood sugar helps prevent kidney damage, blindness, nerve problems, loss of limbs, and sexual function problems.
Objective: The research work aims to find out the quantitative interaction between Levofloxacin and Metformin HCl as well as Losartan Potassium and to identify how much interaction affects the effectiveness of Levofloxacin that has been done by Antimicrobial Analysis.
Methodology: This research work ensures that there is a possible interaction between the Levofloxacin and Metformin HCl and Losartan Potassium which is confirmed by Job’s plot method as well as by the Antimicrobial study. In order to investigate the number of Losartan Potassium and Metformin HCl involved in the complexation with Levofloxacin complexes was demonstrated by exploiting various spectrophotometric methods. The ultraviolet studies of these complexes were carried out and compared.
Findings: The absorbance of Levofloxacin is quite different from the absorbance of Levofloxacin- Metformin HCl and Levofloxacin- Losartan Potassium complexes. Levofloxacin forms a strong 1:1 complex with Metformin and Losartan as ʻ^ʼ shaped curves in the Job’s plot. These curves may indicate strong kinetics of complexation between Levofloxacin and Metformin and Losartan.
By antimicrobial investigation, it is observed that the zone of inhibition of the drug Levofloxacin with Metformin and Losartan is reduced from 12 mm, 10 mm and 8 mm respectively.
Introduction
The danger of drug interactions rises disproportionately as the number of drugs taken rises. The increased risk of harmful drug interactions can be caused by over-the-counter medications. Levofloxacin is an antibiotic that belongs to the third generation of fluoroquinolones (1). Levofloxacin (-)-(S)-9-fluoro-2,3-dihydro-3-methyl-10-(4-methyl-1-pipe-razinyl)-7oxo-7Hpyrido[1,2,3-de]-1,4-benzoxazine-6-carboxylic acid hemihydrate is a Japanese originated synthetic broad spectrum antibacterial agent against Gram-positive and Gram-negative bacteria including Staphylococcus species; Streptococcus pneumonia, Streptococcus pyogenes, Streptococcus hemolyticus, Entero bacter species, Escherichia coli, Salmonella, Klebsiella, Serratia, Enterococcus, Pseudomonas aeruginosa and Proteus species (2). It is a highly effective antibiotic that works against a variety of bacteria. Levofloxacin is used in a variety of bacterial infections, most importantly acute pneumonia (Lung infection), bronchitis (Inflammation of lung passages), skin infections, as well as urinary tract infection (3). A bacterial infection is a condition in which bacteria grow in the body and cause infection. It can target any body part and multiple very quickly. False-positive urine screening results for opiates have been reported in patients using some quinolones. These false-positives are more likely to occur with levofloxacin, ofloxacin, and pefloxacin when used clinically because they produce urinary concentrations sufficient to interfere with commercially available immunoassay kits (4). Confirmation of positive opiate screens by more specific methods may be necessary. Metformin hydrochloride is an oral anti hyperglycemic agent used to lower blood glucose in patients suffering from diabeties of non-insulin dependent. Metformin hydrochloride (Glucophage), chemically is known as 1,1-Dimethyl biguanide hydrochloride with a molecular formula of C4H11N5.HCl (5). It is an oral antidiabetic drug that has been used in the treatment of non-insulin dependent diabetes which improves control of glycemia primarily by inhibiting hepatic gluconeogenesis and glucogenolysis and seems to ameliorate hyperglycemia by improving peripheral sensitivity to insulin, reducing gastrointestinal glucose absorption and hepatic glucose production (6). Recently, metformin has also become available for the treatment of polycystic ovary syndrome and has been found to improve vascular function, prevent pancreatic cancer and revers fatty liver diseases (7). This study is aimed to evaluate the in-vitro complexation nature and strength of complex which may be formed due to interaction between Levofloxacin and Metformin HCl, Levofloxacin and Losartan Potassium and investigation the bioavailability in terms of antimicrobial study of Levofloxacin with them.
Material and Methods
All the chemicals used here were analytical grade and were sorted under optimum storage conditions.
Table 1: List of chemical reagents and source.

Preparations of stock solution (8):
Levofloxacin solution 100 ml of 1×10-2 was prepared by dissolving 0.3614 gm. of Levofloxacin in 100 ml of Demineralized water in a 100 ml volumetric flask. The stock solution was diluted to desired strength by buffer solution.
Preparations of Drug-1 (Metformin HCl) solution:
Metformin HCl solution of 100 ml of 1×10-2 was prepared by dissolving 0.1656 gm. of Metformin HCl in 100 ml of Demineralized water in a 100 ml volumetric flask. The stock solution was diluted to desired strength by buffer solution.
Preparation of Drug-2 (Losartan Potassium) solution:
For the preparation of 0.01M Drug-2 solution, Losartan Potassium (0.461gm) was weighted accurately and introduced with the help of a funnel in a 100 ml volumetric flask, dissolved in demineralized water, and makeup to the mark with the same solvent.
Preparation of Standard curve of Levofloxacin (8):
Levofloxacin stock solution at pH 7.4 and concentration of 1×10-4 M was added in different concentrations to ten test tubes, to have the following concentrations: 9×10-5 M, 8×10-5 M, 7×10-5 M, 6×10-5 M, 5×10-5 M, 4×10-5 M, 3×10-5 M, 2×10-5 M, 1×10-5 M.
The solutions were then properly mixed. The absorbance values of the solutions were determined at 298 nm by UV-Visible Spectroscopy. As a control of reference sample, phosphate buffer solution of pH 7.4 was used. The standard curve was obtained by plotting the absorbance values against the corresponding concentrations.
Results and Discussion
Spectral studies of interaction of Levofloxacin with Metformin (9):
Table 2: Spectral analysis of Levofloxacin with Metformin
| Wavelength (nm) | Absorbance of Levofloxacin | Absorbance of Levofloxacin + Metformin |
| 200 | 0.0050 | 0.0053 |
| 205 | 0.0055 | 0.0060 |
| 215 | 0.0125 | 0.0146 |
| 225 | 3.4183 | 1.6547 |
| 235 | 1.1779 | 0.5893 |
| 245 | 0.8650 | 0.4441 |
| 255 | 0.8834 | 0.4020 |
| 265 | 0.6330 | 0.2795 |
| 275 | 1.0307 | 0.4003 |
| 285 | 4.0575 | 0.6551 |
| 295 | 1.3121 | 0.4262 |
| 305 | 0.4245 | 0.1202 |
| 315 | 0.4000 | 0.1119 |
| 325 | 0.5339 | 0.1939 |
| 335 | 0.6138 | 0.2530 |
| 345 | 0.4852 | 0.2007 |
| 355 | 0.2090 | 0.0738 |

Figure 1: Spectral plot of Levofloxacin and Levofloxacin with Metformin
In x-axis: wavelength In y-axis: absorbance
From the figure we can observe that the absorbance of Levofloxacin is different when it interacts with Metformin.
Spectral studies of interaction of Levofloxacin with Losartan:
Table 3: Spectral analysis of Levofloxacin with Losartan
| Wavelength (nm) | Absorbance of Levofloxacin | Absorbance of Levofloxacin + Losartan |
| 200 | 0.0050 | 0.0022 |
| 205 | 0.0055 | 0.0137 |
| 215 | 0.0125 | 0.0171 |
| 225 | 3.4183 | 3.4310 |
| 235 | 1.1779 | 1.4367 |
| 245 | 0.8650 | 0.8121 |
| 255 | 0.8834 | 0.7404 |
| 265 | 0.6330 | 0.4790 |
| 275 | 1.0307 | 0.4816 |
| 285 | 4.0575 | 0.6405 |
| 295 | 1.3121 | 0.3827 |
| 305 | 0.4245 | 0.0870 |
| 315 | 0.4000 | 0.0805 |
| 325 | 0.5339 | 0.1632 |
| 335 | 0.6138 | 0.2228 |
| 345 | 0.4852 | 0.1748 |
| 355 | 0.2090 | 0.0538 |

Figure 2: Spectral plot of Levofloxacin and Levofloxacin with Losartan
In x-axis: wavelength In y-axis: absorbance
From the figure we can observe that the absorbance of Levofloxacin is different when it interacts with Losartan.
Table 3: Combined Spectral Curve of Levofloxacin and Levofloxacin with Metformin and Levofloxacin with Losartan (11):


Figure 3: Combined Spectral Curve of Levofloxacin and Levofloxacin with Metformin and Levofloxacin with Losartan. This figure shows that the absorbance of Levofloxacin is quite different from the absorbance of Levofloxacin and Metformin and Losartan.
Table 4. Values of Jobs Plot of Levofloxacin and Metformin (12):


Figure 4: Jobs Plot of Levofloxacin and Metformin
From the above figure we can observe that Levofloxacin forms strong 1:1 complex with Metformin which is indicated as ʻ^ʼ shaped curve. This ʻ^ʼ shaped curve confirms the interaction between Levofloxacin and Metformin.
Table 5. Values of Jobs Plot of Levofloxacin and Losartan:


Figure 5: Job’s Plot of Levofloxacin and Losartan
From the above figure we can observe that Levofloxacin forms strong 1:1 complex with Losartan which is indicated as ʻ^ʼ shaped curve. This ʻ^ʼ shaped curve confirms the interaction between Levofloxacin and Losartan.
Table 6. Combined absorbance of Levofloxacin and Levofloxacin with Metformin and Levofloxacin with Losartan at different concentration:
| Levofloxacin | Levofloxacin + Metformin | Levofloxacin + Losartan |
| 0.0211 | 0.0613 | 0.1250 |
| 0.1148 | 0.1716 | 0.2685 |
| 0.2357 | 0.3944 | 0.3802 |
| 0.3322 | 0.5553 | 0.4601 |
| 0.5025 | 0.5739 | 0.5980 |
| 0.7408 | 0.7589 | 0.7842 |
| 0.8568 | 0.8914 | 0.8188 |
| 0.9222 | 0.9294 | 0.8648 |
| 0.9819 | 1.0053 | 0.9261 |

Figure 6: Combined absorbance of Levofloxacin and Levofloxacin with Metformin and Levofloxacin with Losartan
The above figure shows that the absorbance of Levofloxacin differs from the absorbance of Levofloxacin + Metformin and Levofloxacin + Losartan due to interaction.
Activity against gram-positive bacteria (13)
The test samples were tested against Staphylococcus aureus. The standard Levofloxacin disk also tested against Staphylococcus aureus. The results of the antimicrobial activity, measured in terms of diameter of zone of inhibition in mm are showed in table.

Figure 7: Evaluation of antimicrobial study of Levofloxacin with Metformin and Losartan.
In the figure-
L: Levofloxacin Solution
L+M: Levofloxacin + Metformin Solution
L+L: Levofloxacin + Losartan Solution
Conclusion
This research work ensures that there is a possible interaction between Levofloxacin with Metformin and Levofloxacin with Losartan. This research work has been done by two methods one by UV-Visible Spectroscopic method and another one by antimicrobial study.
For the UV-Visible Spectroscopic method, the standard curve for Levofloxacin, Metformin as well as Losartan is prepared and their absorbance vs concentration curve is almost linear means the absorbance is increased with increasing their concentration.After that the spectrum curve of Levofloxacin is measured at a different concentration from 200-355 nm then this spectrum of Levofloxacin compared with the spectrum of Levofloxacin + Metformin mixture and Levofloxacin + Losartan mixture, Levofloxacin spectrum curve is quite different from each other. From these spectrum differences, we would primarily guess there is a possible interaction between Levofloxacin with Metformin and Levofloxacin with Losartan, which will be proved via job's plot in the next stage.In the job's method, a vital method for this research work, it has been seen that Levofloxacin forms strong complexes with Metformin as well as Losartan when they are mixed at a 1:1 ratio (pH 7.4) and provides a “ ^ ” shaped curve that confirms the interaction has occurred between Levofloxacin with Metformin as well as Losartan which ultimately affects the antimicrobial activity of Levofloxacin. For the Antimicrobial study, Levofloxacin have been tested against Staphylococcus aureus and Escherichia coli bacteria and the test have been done via disk diffusion method. Antimicrobial activity confirmed that the zone of inhibition of Levofloxacin, Levofloxacin with Metformin and Losartan against Staphylococcus aureus (gram positive bacteria) is lowered from standard disk 16mm to 12 mm, 10 mm and 8 mm respectively. This represents interaction between one another. But the zone of inhibition of Levofloxacin with Metformin and Losartan against Escherichia coli (gram negative bacteria) don't show any notable antimicrobial effect. It is known to us; the availability of the drug represents the amount (quantity or concentration) of the drug. It helps in the study of the selection of the best dosage form for treatment. And very important in adjusting the effective dose and dose ranges.
References
- Qato DM, Wilder J, Schumm LP, Gillet V, Alexander GC (April 2016).
View at Publisher | View at Google Scholar - Tannenbaum C, Sheehan NL (July 2014).
View at Publisher | View at Google Scholar - Shargel L. Comprehensive pharmacy review. Lippincott Williams & Wilkins, 2010.
View at Publisher | View at Google Scholar - Herfindal ET, Hirschman JL. Clinical pharmacy and therapeutics. Williams & Wilkins; 1979 Dec 1.
View at Publisher | View at Google Scholar - St. James Hospital, Drug Interactions, Available from: http://www.stjames.ie/GPsHealthcare Professionals/Newsletters/NMICBulletins/NM ICBulletins 2000/VOL6-4Drug%20Interactions.pdf,
View at Publisher | View at Google Scholar - James M Ritter, Lionel D Lewis, Timothy GK Mant and Albert Ferro, A Textbook of Clinical Pharmacology and Therapeutics, Fifth edition, Hodder Arnold, an imprint of Hodden Education, part of Hachette Livre UK, Available from: http://www.pharmaresearchlibrary.com/wp-content/uploads/2013/03/A-Textbook- of Clinical-Pharmacology-and-Therapeutics-5th-edition.pdf.
View at Publisher | View at Google Scholar - Malgor Valsecia, Farmacologia general: Farmacocinética. Cap. 2. en
View at Publisher | View at Google Scholar - Elizabeth Lipp (2008-06-15). Tackling Drug-Interaction Issues Early On. Genetic Engineering & Biotechnology News. Mary Ann Liebert, Inc. pp. 14, 16, 18, 20. Retrieved 2008-07-06. (subtitle) Researchers explore a number of strategies to better predict drug responses in the clinic. Online version:
View at Publisher | View at Google Scholar - IUPAC. Compendium of Chemical Terminology, 2nd ed. (the "Gold Book") (1997). corrected "cytochrome P450". doi:10.1351/goldbook CT06821 Danielson PB (December 2002). "The cytochrome P450 superfamily: biochemistry, evolution and drug metabolism in humans". Current Drug Metabolism. 3 (6): 561-597.
View at Publisher | View at Google Scholar - Schubert J. Chelating agents in biological systems. Environmental health perspectives. 1981 Aug; 40:227.
View at Publisher | View at Google Scholar - Singh Y. Martin's physical pharmacy and pharmaceutical sciences. Department of Pharmaceutics Ernest Mario School of Pharmacy Rutgers, The State University of New Jersey. 2006.
View at Publisher | View at Google Scholar - DeFord DD, Hume DN. The determination of consecutive formation constants of complex ions from polarographic data. Journal of the American Chemical Society. 1951 Nov;73(11):5321-5322.
View at Publisher | View at Google Scholar - Sultana NA, Arayne MS, Sharif SA. Levofloxacin interactions with essential and trace elements. Pakistan journal of pharmaceutical sciences. 2004 Jul;17(2):67-76.
View at Publisher | View at Google Scholar

 Clinic
Clinic
